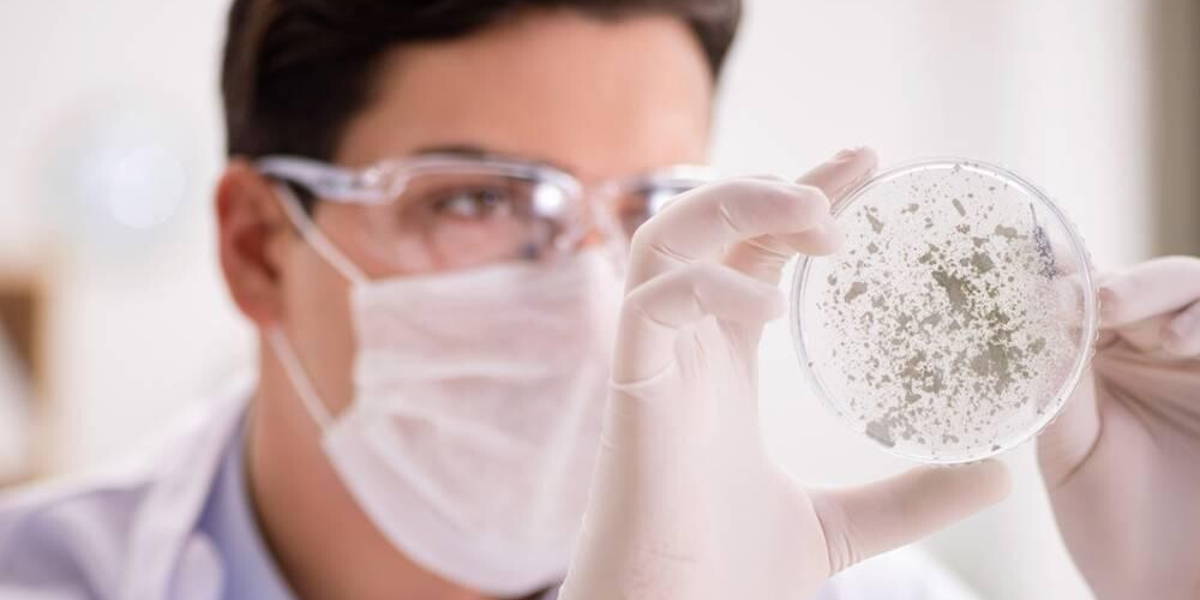
Virus-Vaccin-Onderzoek-Lab

De afgelopen weken hebben 'hackers' van over de hele wereld in 70 landen deelgenomen aan tientallen de 'Hack the Crisis' hackathon's die georganiseerd zijn. Tijdens die evenementen gingen deelnemers op zoek naar concrete coronacrisis oplossingen voor onder andere de zorg, onderwijs op afstand, logistiek en mkb-steun. Afgelopen weekend werd deze hackathon in Amsterdam georganiseerd.
De jury maakte na rijp beraad vier winnaars, in de genoemde categorieën, van de Nederlandse hackathon, bekend. Zij gaan, met de toegezegde steun van diverse organisaties, variërend van multinationals tot gemeenten en zorg- en onderwijsinstellingen, hun oplossingen verder ontwikkelen in de hoop dat ze snel een impact kunnen maken op de huidige crisis. Wij zijn in het bijzonder geïnteresseerd in de oplossing op zorggebied; een innovatieve manier om de zoektocht naar een coronavaccin te versnellen.
Puzzelen voor een coronavaccin
De zoektocht naar een vaccin tegen COVID-19 is een van de grootste medische uitdagingen van dit moment. AnalysisMode bedacht een oplossing waarmee het voor iedereen mogelijk wordt hier een bijdrage aan te kunnen leveren: een online puzzel. De input van de deelnemers zorgt er vervolgens voor dat het voor kunstmatige intelligentie mogelijk wordt de vaccinformule voor COVID-19 te voorspellen.
De zoektocht naar een vaccin voor een (nieuw) virus is letterlijk ook een puzzelopdracht. Een virus is gemaakt van eiwitsequenties die elk gevormd worden door 50 tot 100 aminozuren. Elk aminozuur is als een individuele kraal. Aan elkaar geregen vormen ze een eiwit. Net als in sieraden vormen individuele kralen een ketting. Wanneer een virus ons infecteert, maakt ons immuunsysteem afweercellen vrij. Deze cellen scannen organismen in onze bloedbaan op zoek naar een specifiek onderdeel dat een epitoop wordt genoemd. Een epitoop is als een streepjescode die aangeeft of het organisme tot het lichaam behoort of dat het een indringer is.
Om ons lichaam te leren specifieke epitopen als een virus te herkennen, moeten we een formule voor dat epitoop vinden. Die formule moet in een laboratorium gemaakt worden en vervolgens als vaccin toegediend worden. Onze afweercellen kunnen vervolgens de "barcode" van dit epitoop scannen. Daarmee herkennen dat het een indringer is en het afweersysteem voorbereiden op een gevecht voor het geval een echt virus ons lichaam binnendringt.
Inmiddels hebben al meer dan 7000 deelnemers in 93 landen de puzzel gespeeld. Om het platform verder te ontwikkelen en tot mogelijk concrete resultaten te komen werkt AnalysisMode nu samen met de Universiteit van Oxford.
Haalbare oplossingen
“De jury heeft bij hun beoordeling nadrukkelijk gekeken naar de haalbaarheid van de oplossingen. Voor de winnaars begint nu het harde werk om hun impact ook echt te realiseren", zegt projectleider Sebastien Toupy van TNW.
Behalve de toegezegde steun voor de winnaars van diverse betrokken organisaties, waaronder Yes!Delft, Smart Health Amsterdam and Sanquin, biedt het platform coronacommunitycare.nl alle andere teams ook een kans om hun projecten verder te ontwikkelen.